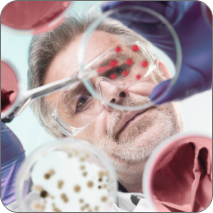

Onco-PDO™️ is the latest in Precision Oncology
Created to assist in decision making for oncological treatments, this test allows an analysis of the tumor’s response to different combinations of chemotherapy and molecular target therapies, helping to determine a 100% personalized, much more effective and assertive treatment.
The Onco-PDO™️ Test is performed from tumor material, extracted by biopsy or puncture. The collected cells undergo culture and treatment, generating clusters genetically identical to the tumor, called PDOs (Patient-Derived Organoids).
From these, in-vitro 3D models are created to which the treatment possibilities chosen by the physician are applied. The tumor response is quantified and analyzed for each combination of drugs and therapies, making it possible to identify which will be more assertive for that patient, individually.